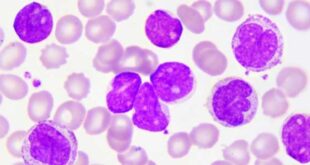

Η σύγχρονη αντιμετώπιση των ασθενών που πάσχουν από χρόνια λεμφογενή λευχαιμία (ΧΛΛ) και οι οποίοι έχουν ένδειξη για θεραπευτική αντιμετώπιση, στηρίζεται στη χορήγηση αναστολέων της τυροσινικής κινάσης του Bruton (BTK αναστολείς). Η πλειονότητα αυτών των ασθενών ανταποκρίνεται σε αυτές τις θεραπείες, αλλά συνήθως μετά από κάποιο χρονικό διάστημα αναπτύσσεται αντοχή σε αυτά τα φάρμακα. Οι ασθενείς με χρόνια λεμφοκυτταρική λευχαιμία …
Περισσότερα » Health Update Health Update
Health Update Health Update